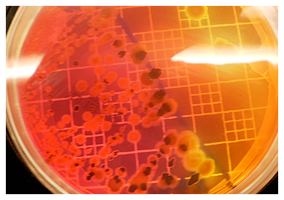
legio2

L’offerta di Biochem si distingue per essere personalizzata e su misura delle esigenze del cliente; essa è inoltre diversificata e ampia. Biochem ha iniziato la propria attività come laboratorio per il controllo microbiologico di prodotti alimentari e per il controllo di Dispositivi Medici.

BIOCOMPATIBILITA’
I test previsti dalle norme ISO 10993 e USP per la valutazione della sicurezza dei materiali impiegati in campo biomedico hanno lo scopo di evidenziare i rischi potenziali e prevedibili connessi all’uso sull’uomo.
Biochem vanta esperienza pluridecennale, personale altamente qualificato, referenze di primo piano, ed è il giusto partner per il raggiungimento dei vostri obiettivi.
Biochem, oltre all’attività di esecuzione delle prove, fornisce un servizio di supporto nella scelta dei test da eseguire, delle modalità di conduzione specifiche per il dispositivo o il materiale da esaminare, anche attraverso la stesura di Razionali per la scelta delle prove e di Protocolli operativi.
Vedi Elenco completo, se non trovi la prova di tuo interesse contatta il nostro Ufficio Commerciale.

TEST DI EFFICACIA
Biochem avvalendosi di professionisti di comprovata esperienza è in grado di offrire ai propri clienti un Servizio completo per la verifica della efficacia di dispositivi medici. Offriamo test di screening e test nel protratti nel tempo per verificare l’efficacia verso varie patologie quali ad esempio: asma da allergia, colite, riniti, sinusiti, dermatosi/dermatiti, ma non solo. Gli studi sono preceduti dalla condivisione dei protocolli sperimentali personalizzabili in funzione delle esigenze del cliente e delle forme fisiche o modalità di somministrazione.
Se non trovi la prova di tuo interesse contatta il nostro Ufficio Commerciale.

REPROCESSING FDA
Biochem è in grado di studiare i protocolli più adeguati per voi in base al tipo di dispositivo, alla sua criticità e impiego per la validazione del reprocessing sia sotto il profilo microbiologico che di pulibilità e assenza dei residui della disinfezione.
Abbiamo una esperienza consolidata di successo di diverse registrazioni di reprocessing, prezzi e tempi sicuramente competitivi con i più affermati laboratori internazionali.
Per ogni esigenza e problematica contatta il nostro Ufficio Commerciale.

EXTRACTABLES E LEACHABLES
Biochem offre un approccio completo all’analisi e valutazione degli Extractables/Leachables. Il nostro approccio unisce competenza esperienza tecnica e analitica, conoscenza dei polimeri e degli elastomeri, comprensione dei requisiti regolatori per tipo di impiego, Il servizio è contraddistinto da un approccio personalizzato alle esigenze dei clienti.
What are extractables and leachables?
Extractables are compounds that can be extracted from a component under extreme conditions, such as the presence of harsh solvents or elevated temperatures.
Leachables are compounds that leach into the drug product formulation from the component as a result of direct contact with the formulation under normal conditions; they are typically a subset of extractables. These compounds, both organic and inorganic substances, come from plastic components, elastomers, coatings, accelerants, antioxidants, inks, vulcanizing agents, additives, residual solvents or derive from degradation processes. Phthalates are one specific example. As new delivery devices, disposables, and medical devices are developed, it is certain that FDA will continue to demand information about these components so that the agency can make informed decisions on risk and safety. For this reason the development of E/L testing is of increasing importance.

TOSSICOLOGIA
Gli studi di tossicologia permettono di valutare le interazioni tra le sostanze e i sistemi biologici, al fine di determinare possibili effetti avversi sulla salute. La tossicologia si propone di valutare la natura e l’incidenza di tali effetti sugli organismi viventi, attraverso l’esame delle alterazioni biologiche indotte.
Biochem vanta esperienza pluridecennale, personale altamente qualificato, referenze di primo piano, ed è il giusto partner per il raggiungimento dei vostri obiettivi. Biochem effettua i test tossicologici e di biocompatibilità richiesti dalle varie Farmacopee, dalle norme UNI EN ISO 10993, scelti in base alla tipologia di dispositivi, alla loro invasività, alla durata e tipo di contatto con i tessuti umani. La caratterizzazione chimica dei materiali componenti i Dispositivi Medici è una parte preliminare ed essenziale degli Studi di Biocompatibilità, che avrà importanza crescente per il rispetto del Benessere animale.
Vedi Elenco completo, se non trovi la prova di tuo interesse contatta il nostro Ufficio Commerciale.
ANALISI MICROBIOLOGICHE
Eseguiamo test di microbiologia su diverse matrici: alimenti, acque, prodotti cosmetici, dispositivi medici, preparazioni farmaceutiche, aria e superfici di lavoro per tutti gli ambienti controllati (ad esempio nel Settore Ospedaliero; della produzione di Galenici, Dispositivi Medici, della Produzione in asettico, della Ristorazione …).
I Test microbiologici sono volti alla ricerca quali-quantitativa di microrganismi e al controllo di sterilità.
Biochem esegue anche
- prove di batteriostaticità di materiali plastici, metallici, e altri materiali per vari impieghi
- prove di efficacia di agenti sanificanti, disinfettanti, sterilizzanti;
- prove di sterilizzabilità.
Vedi Elenco completo, se non trovi la prova di tuo interesse contatta il nostro Ufficio Commerciale.

ANALISI CHIMICHE
Eseguiamo test chimici su diverse matrici: alimenti, acque, gomme e materie plastiche, dispositivi medici, materie prime.
Il nostro laboratorio può applicare, dove esistenti, metodiche ufficiali (UNI, IRSA, ISO, EPA, FDA, etc) per la ricerca quali-quantitativa di sostanze quali metalli, additivi, plastificanti, Ftalati, monomeri residui, VOC, residui dei processi di pulizia o di sanificazione disinfezione e sterilizzazione; Biochem effettua le prove previste per i nebulizzatori dalle varie norme internazionali.
Vedi Elenco completo, se non trovi la prova di tuo interesse contatta il nostro Ufficio Commerciale.

IMBALLAGGI E MATERIALI A CONTATTO CON GLI ALIMENTI PER DISPOSITIVI MEDICI
Gli imballaggi e i materiali a contatto con gli alimenti debbono essere prodotti applicando lungo tutta la filiera le Buone Pratiche di Fabbricazione.
Biochem offre servizi per verificare le caratteristiche degli imballaggi, ai fini del rispetto delle relative norme di alimentarietà o protezione e conservazione del prodotto, in rapporto al materiale contenuto. Gli imballaggi per Dispositivi Medici debbono assicurare principalmente il mantenimento della sterilità nei casi in cui il prodotto viene posto in commercio dopo sterilizzazione.
Alcune categorie di test disponibili:
Caratterizzazione chimica dei materiali, Test di tenuta, Prove chimico-fisiche, Test di barriera ai microrganismi, Test di penetrazione del colorante, Test di cessione, Invecchiamento accelerato, Test di sterilità. Possiamo elaborare protocolli specifici per prove non normate e eseguire la convalida dei metodi da utilizzare. Principale legislazione di riferimento: FDA 21CFR, 2010/11/CE, DM 21/03/1973
Vedi Elenco completo, se non trovi la prova di tuo interesse contatta il nostro Ufficio Commerciale.

PROVE DI STABILITÀ
Nel settore farmaceutico, alimentare, cosmetico e dei Dispositivi Medici, la stabilità delle sostanze attive deve essere testata e documentata per assicurare e dimostrare il mantenimento delle proprietà del prodotto. Biochem è in grado di progettare e effettuare studi di stabilità del prodotto, ad esempio in conformità con le linee guida ICH e altri Standard. Possiamo effettuare prove in svariate condizioni di temperatura e umidità relativa, per simulare diverse situazioni d’uso e di conservazione nel tempo.
Da queste prove scaturiscono informazioni indispensabili per valutare la shelf life del prodotto e garantirne l’efficacia. Possiamo elaborare protocolli specifici per prove non normate e eseguire la convalida dei metodi da utilizzare.
Se non hai trovato la prova o il servizio di tuo interesse contatta il nostro Ufficio Commerciale.

AMBIENTI CONTROLLATI, CONVALIDE, CONTROLLO DELLE TARATURE
Biochem offre servizi per la valutazione degli ambienti e dei processi controllati, al fine di verificare e monitorare l’adeguatezza degli ambienti, delle apparecchiature e delle procedure, e la rispondenza alle norme previste. Tutte la attività di convalida sono basate su un approccio di analisi del rischio. Biochem esegue la misura della contaminazione particellare e conteggio dei microrganismi nell’aria di tutti gli Ambienti Controllati, della Camera Bianca, delle cappe o zone che richiedono controlli specifici dell’aria per valutarne il grado di pulizia, in accordo alle norme ISO 14644 e ISO 14698.
Biochem offre anche: procedure operative del personale e procedure di pulizia sanitizzazione (ambienti, macchine; valutazione dell’efficacia degli impianti di trattamento condizionamento aria e fluidi di processo; definizione dei parametri ambientali di riferimento; convalida dei processi di sanitizzazione, pastorizzazione, sterilizzazione, inattivazione di virus; controlli particellari e microbici; corsi di addestramento del personale.
Vedi Elenco completo, se non trovi la prova o il servizio di tuo interesse contatta il nostro Ufficio Commerciale.